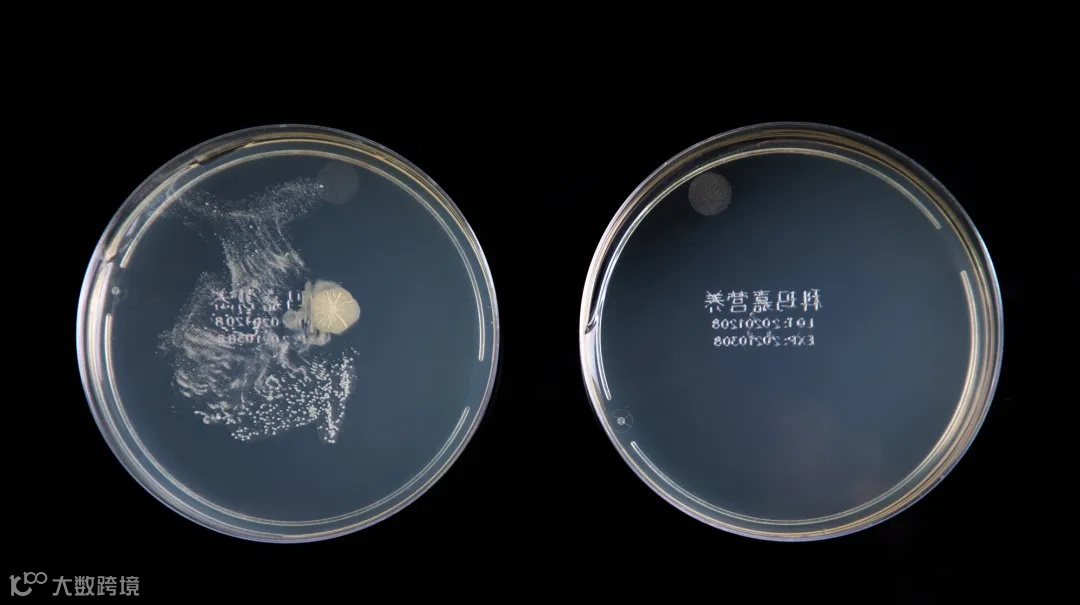

便宜好用,解锁N+厨房好物
砧板&削皮器&围裙
原价¥39
普象价¥9.9起
LC LIVING是专注于天然木材的泰国百年木质厨房用品制造商。
品牌源自泰国佛教文化,创始人祖祖辈辈都是佛匠,从事佛像的雕刻、修复工作,后来才将传统的佛像黏合技术和木工手艺运用到现代的厨房木制品的生产中。

格子砧板不仅是摆盘神器,更是名副其实的老网红!
格子菜板是LC LIVING的原创设计。他们的设计师KANUENGPORN创作于2015年,但2017年才投入中国市场,之后就开始出现越来越多的同款。

用的是小叶野生相思木拼接而成,每一块木头纹路都不太一样,样子好看,质感也好!
相思木为原料的厨具不易残留细菌,木质密度高,菜板用刀切不会掉渣,也不易渗入汁液,是厨房用品材质的最佳选择之一。

相思木木质结构细密,切面光滑。
天然木纹清晰生动,可媲美胡桃木。
它的强度、抗冲击韧性、耐腐性都很强,用来做砧板非常合适。


菜板的粘合均使用泰国天然乳胶,与自然木材完美融合。
这种天然材质的无缝拼接,不仅稳定性高,也不易滋生细菌。

无甲醛、无工业胶水、无有害油漆,可作为婴儿厨房辅食菜板。

相思木的密度在0.6-0.8之间,属于木材中较为“柔软”的,可以很好地保护刀刃。

【典藏款】东方之冠实木菜板
加宽加厚,日常有坎剁需求的朋友,推荐LC LIVING这款典藏系列,同样360度无死角的美~

砧板的设计灵感源自世博会中国馆造型
虽然也是拼接的设计,但不似格子砧板的黑白深浅错落,这款的配色整体更和谐,低调的棕红色更加迷人大气,非常具有收藏意义!

尺寸48x36x3.5(含脚垫4.5)cm
每一块砧板用的都是50年以上树龄的相思木制作,
由经验老道的工艺师傅拼接而成。极好的木材加上极佳的手艺,完全工艺品级别的享受!

这款底部加了防滑脚垫,有水的台面也不会滑来滑去
加厚材质,切菜备菜用起来也更稳定。

除了东方之冠系列,LC LIVING这次还有—
棋盘格案板,有多种规格可选,小的可以直接摆拍端上桌,大号加厚款适合砍剁、揉面。

带集水槽的皇后独家款!

尺寸45x30x2.5(含脚垫3.5)cm
这次给大家准备了6个款式,而且普象还有优惠价,入手不亏!
还有一些厨房小物,不贵但好用,能大大提高做饭的幸福感。
德国CS鎏金系列不锈钢削皮刀,颜值就赢了。

锋利到尖叫!
牛油果、猕猴桃、连超难搞的土豆, 贴着果肉轻轻一刮皮就「唰 ——」地下来了。削得又薄又均匀,而且完全不会伤到手。

手柄鎏金工艺,低调又奢华!

握感超舒服,削半小时苹果都不带累的
经常做饭的人肯定少不了一条好围裙!
设计出来这个可拆卸擦手巾围裙的真的太懂生活了❗️❗️❗️

终于不用做饭做到一半出去找卫生纸擦手了,

这个毛巾还是可拆卸的,脏了直接拆下来洗干净,也太太太方便了吧!

围裙表面防水防污,内里还有点绒绒的感觉,非常亲肤

而且是交叉式肩带,再也不用喊人帮忙系围裙了!

让洗发回归本真
将象和侧柏叶何首乌洗发皂
原价¥39
普象价¥19.9起
一头蓬松浓密的秀发才是高级感绝杀!
就算五官没有那么精致,人群中一站就是干净清爽的气质。

但很多人洗完头半天就贴头皮、痒起来还飘“雪花”、长痘痘、落发,每天为头发问题发愁。

换了无数瓶洗发水,去屑的太干,控油的太涩。现在越来越多人开始用“洗发皂”替代洗发水。
比如这块将象和古法侧柏叶何首乌洗发皂!

养头发,其实就是养头皮。
如果把头皮比作“地”,长期使用化学肥料,时间长了地也会“坏”
头皮是一样的,得温和去养,才会焕发活力!

怎么养头皮!靠老祖宗的手艺:
将象和洗发皂含有多种植物成分,这就是“养地”的肥料!


说说我自己的使用感受
洗发皂赠送的起泡网搓泡蛮快,洗完头发涩涩的,没有之前洗发水的假滑感。
用了半个月发根不油了!!我可是头油星人!甚至能撑3天不洗头!

一个月左右洗澡发现冲掉的头发少了,非常吃惊!




夏季脚部烦恼有救了
荷兰Preminal足部抑菌喷雾
原价¥39
普象价¥19.9起
给大家推荐一瓶足部喷雾:荷兰Preminal足部抑菌喷雾

只喷了三天,脚后跟轻微症状就有了明显改善。


市面上足部抑菌喷雾真不少,但大多都只添加了一种核心抑菌成分。

Preminal实验室历经千次实验,反复调试比例,研究出了一个最佳配方:
两大核心抑菌成分:0.158%浓度苯扎氯铵+0.329%浓度癸甲氯铵

医院手术器械、医疗设备消毒,术前皮肤消毒、伤口消毒...经常会用到这两种成分。
两种成分本身“单兵作战能力”就很强了。
双效合一,抑菌能力更强,效果更好!

权威实测认证:
对大肠杆菌、金黄色葡萄球菌、白色念珠菌等常见致病菌,抑菌率>99.96%。


找来了一双同事大哥平时穿的鞋,用棉签往鞋里蹭了蹭。

在其中一个真菌培养皿里喷上足部抑菌喷雾,过段时间再看。
没喷喷雾的培养皿(左)里大片的真菌,而另一个毛都没有。
Preminal足部抑菌喷雾“无色无味”,不含香精、激素、重金属等刺激性物质。
实测pH值6.15,温和弱酸性。完美匹配咱们足部皮肤的天然环境,温和好吸收。

因为是喷雾状,脚丫、袜子、鞋子、鞋柜、床上...都能喷,形成抑菌闭环。

尤其是孩子,每天在外面乱跑,脚丫汗滋滋的,容易滋生菌。
家长可以在孩子出门前,先给脚丫、鞋袜都喷一喷。
一瓶只有一部手机大小,随手塞包里,随时拿出来喷,出差党、健身党出门必备!

剪指甲居然还能这么简单!
沃品电动指甲刀M7旗舰版
原价¥159
普象价¥109起


它这个电动刀头配了超硬的合金刀片,运作起来嗡嗡的带劲,跟冲击钻那个劲儿差不多!

马达动力贼猛,剪起来嗖嗖的,打磨也顺滑得很,一点不拖泥带水!
别说普通指甲了,连爷爷奶奶那种又厚又硬的指甲都能轻松修剪!
两档调节功能:
🐣 宝宝模式:慢速温柔,修剪嫩指甲不发抖
👴🏻 成人模式:强力快剪,厚硬指甲一刀过

修剪+抛光一气呵成
现在上班前随手一磨就能拥有圆润漂亮的指甲,本都市丽人表示很满意!

换上锥形合金打磨头,它又化身细节怪,角角落落都帮你打磨的干干净净!

最贴心的是自带'甲屑保险箱'!
剪下来的指甲自动收进小盒子,再也不会飞的满屋都是,用完轻轻一倒就搞定,强迫症表示极度舒适!

终于等到Type-C接口的指甲剪了!
和手机共用充电线不说,续航还特别顶,实测充1小时能用60天,放浴室偶尔用一次半年不充电都没问题~
这款指甲刀还自带照明,光线明亮但不剌眼

我愿称之为洗澡之神
浴见·乌檀木猪鬃沐浴刷
原价¥199
普象价¥159起


|

|
平价洗澡刷大多刷毛是平价的尼龙,浴见用100%猪鬃毛
猪鬃弹性、韧性好,还有天然吸附油脂的特性,尤其适合头发、身体护理,不是尼龙、塑料可以比得上的。
我用的是软毛,敏皮友好,刷毛毛峰细软、不刺手,触感舒服。


搓泥儿本身是个治愈的事,而猪鬃毛浴刷兼具清洁和温和,还是个放松神器!
乌檀木猪鬃浴刷的接触面积更大,且拥有 3 项专利。
专利一:防水垫片(实用新型专利:ZL201820734432.9)
专门在每把刷子里内置了防水垫片,隔绝刷毛上的水渗到木柄里,降低开裂发霉机率。

触感柔软,细腻亲肤,薄皮、易敏肌肤也友好

符合「人体工学设计」的手柄弧度加上「透明喷砂防滑工艺」方便手握施力,再湿滑也不易脱手


100% 猪鬃毛,软硬适中,触感柔韧,遇水变软,刷起来不会太痛。
不仅搓掉了老废角质,还相当于按摩到了皮肤。

乌檀木质感细腻显贵气,握感温润趁手,举久了也不会累。



穿上像减龄瘦身
韩系纸片人套装
原价¥179
普象价¥79
墙裂安利!这套风靡韩国的神仙百搭套装—韩系纸片人套装
79元就能穿出韩剧女主既视感,显瘦到闺蜜以为我偷偷去减肥了!

重点来了:细节满满的设计感!简直把女孩子的需求拿捏得SS的!!
1️⃣ 抽绳+裙摆设计,小肚子都能藏住(亲测有效!)
2️⃣ 面料冰凉凉的超舒服,夏天穿像自带小空调
3️⃣ 分开搭配能穿出七八套look,性价比炸裂!

褶皱自然堆叠的设计真的太心机了,既能藏肉又不会勒得难受~
加上它下摆的微扩设计,完美遮住假胯宽!
秒变体态身材火辣的大美女~

有麒麟臂的姐妹完全不用担心,立体剪裁的半袖,对粗手臂人士超友好~

关键是,它贴合了人体结构,遮住副乳的同时
腋下胸部位也能被稳稳遮盖“不良视线”,安心不走光!

a字版型,让大象腿的我,穿上之后小肉肉都隐形了

正面看: 腿细得像90斤,萝卜腿型瞬间笔直了~
侧面看: 日本的漫画腿既视感,完全看不见大腿根肉肉
内置安全裤:走路再也不怕走光~

它用的是凉感冰丝再生面料+独创针织技术
回家脱下来居然还有淡淡凉意
男朋友摸了一把惊呼:"你这裙子挺好摸呀,凉凉的很舒服"

没有飞织包,真不好过夏天呢!
一体化编织环保飞织包
原价¥299
普象价¥149







因为全部是编织的,所以包包摸起来非!常!软!

饱满柔韧舒适肩带,肩带上身不勒肩,可腋下、手提、手挽,贴合肩型,减轻肩部压力~

Seven Molly是小众设计师品牌,不易撞款之外,品牌溢价也低。
包包平时售价在299-499,今天我们给大家谈到了百元出头,低至149元起,相当于官网价的半价。


19.9元买大牌运动裤
真维斯运动休闲短裤
原价¥99
普象价¥19.9(2条起购)

从面料到做工,从细节到版型,再加上 19.9 一条的价格,真的!拿到夜市摆摊,49 一条卖都绝对好卖。

先讲一下它的面料。
是用的凉感冰丝面料,超级轻薄,仅普通裤子一半厚。
自带凉感,39°C 高温下仍能保持 “凉飕飕” 体感~

看走线,比很多100+的同类产品都要精细。

两侧口袋还带有高密拉链,手机钥匙狂甩不掉!

加宽腰头 + 可调节抽绳,适配啤酒肚、瘦腰等不同腰围。

如果你穿过带拉链的裤子,换一条不带拉链的裤子,就会明白「多两个拉链口袋,安心程度、方购便程度翻十倍」
出门玩,东西装里面,拉链一拉,跑跳坐躺,完全不用担心东西会掉。

久坐久就要坐舒服点儿
米乔空气坐垫
原价¥199
普象价¥98起
我们在一众品牌中给大家找到一款宝藏坐垫:减压舒适,清爽透气,久坐一天都不累!!
它就是——米乔空气坐垫

首先,这款坐垫能够减压缓震,坐垫上有46颗减震气囊,柔软Q弹!
向上能承压,这些气囊当受到挤压时,能够通过气体间流动产生“反重力”效果,可缓冲压力;
向下能减震,通过3D气囊内的气流通道,可分散垂直压力平衡受力点,达到减震效果。

为此我们做了测试:
同样把鸡蛋丢在椅子上,没有坐垫的时候,鸡蛋直接摔碎了;但放上米乔坐垫,鸡蛋扔下去完好无损!

|

|
坐上去更是舒适!
坐垫设计更是妥妥人体工学:均衡释压的小气囊、符合人体曲线的大凹槽、还有承托平稳的大气囊…

气垫背面设计了充气密封孔,需要充气的时候按三四下就能充满。


而新升级的水冷版坐垫,在此基础上更是将清凉进行到底!
原理采用不易吸收热量的惰性温感材料,能大幅度降低热能传导,夏日也不容易受到环境高温影响,从而起到体感降温的作用
三层面料设计,从内到外有调温清凉层、透气TPU和外层的氨纶纤维,透气又清凉!

这样的设计,带来了全方位动态支撑和多角度包裹,
人坐上去臀部能更好地释压,久坐也轻松~

夏天高温炎热,坐久了酸痛不舒服,还容易闷汗!
新款水冷坐垫,坐垫中加入了不易吸收热量的惰性温感材料,能大幅度降低热能传导,带来体感降温~

品牌那边还做了热感对比测试:
坐在普通棉坐垫上,测试人体体感温度是38.6℃;而坐在米乔水冷版坐垫,人体体感温度只有26.4℃,厉害了!

在太阳下暴晒十分钟,没有放坐垫的车座温度高达53.2℃;
但放了米乔坐垫的车座,温度直接降到了30.6℃,效果简直不要太明显!!!


一个小东西让灶台降温 20 ℃
蓝宝2025年新升级的X6冰厨宝
原价¥499
普象价¥369
这气温一到七月,就噌地坐上了火箭,直冲 40 ℃ 大关。
一踏进几平米的厨房做饭,不到 5 分钟,那高温,跟大中午站在柏油马路上不相上下!
今年,终于被我挖到宝了!它就是蓝宝2025年新升级的X6冰厨宝,

它有啥与众不同之处,简单来讲,普通风扇在夏天只能吹出热风,但冰厨宝就像「空调 + 循环扇」的结合体,机如其名,仿佛是把冰箱的冷气浓缩成一道道循环立体风。
吹出来的风冰冰凉凉的,让你知道什么叫「清凉下厨」!

● 风够凉:自带冰爽粒子的风,快速降温,抵挡大火爆炒时的扑面热浪;
● 风够猛:送风距离达到 7 m,可以实现 70° 上下手动调整角度、120° 左右摇头,风速强劲的同时不影响灶台火苗;
● 油污好清洁:厨房爆炒溅起的油烟,用抹布简单擦一下就干净得像新机一样;
● 小巧免安装:走到哪凉到哪,像夏日卫生间、饭桌、客厅、阳台、化妆台都能用;
● 主打省电省钱:月电费 ≈ 1 元,怎么用都不心疼。
● 一机多能:夏天当移动小空调,春秋可当普通风扇,冬天可作为加湿器。

咱们直接测温看看,在相同皮肤温度下(30 ℃),分别用循环扇和冰厨宝直吹皮肤,结果显示—
只过了 10 秒,循环扇降温 2 ℃,而冰厨宝足足降了 10 ℃。

再看测灶台边的体感,在开火的灶台边,皮肤表面温度高达 54.2 ℃。
开启冰雾扇吹了会,再测皮肤温度变成了 33.9 ℃,快速降低了 20.3 ℃

|

|


这么小的家伙,凉气怎么来得又快又足?
ICE APEX冰极微粒降温技术,通过每秒 170 万次高频震动,将内置水箱里的水分子瞬间震成「冰粒子」,这些粒子与空气混合后形成低温雾气,伴随风力加速蒸发吸收热量,来实现快速降温。
不管你加的是常温水、还是热水,吹出的风都是凉风,完全不用刻意加冰水,真的超级省事!

它风力够大够远,能让半个厨房都凉快下来
这要得益于它使用了航空级电机配上 22 叶仿生海鸥扇叶,能输出7 m/s 高风速。
不管你是在灶台边,还是洗菜池,都能感受到嗖嗖凉风。


开启后直接火力全开,触发最强降温效果,风速和出雾都直接飙到 120%,降温效果立竿见影!

它还可以做到左右摇头 120° + 上下摆动 70° 灵活送风,
无论厨房的台面是怎么样的,在运行中咱们可以任意角度定点和吹风,让凉风精准吹向你,避开灶台明火。

不小心机器上溅上了污渍,用湿抹布轻轻一擦,就干净得像新机一样,打理起来贼方便。

操作起来也十分简单,直接水箱注水,也可以打开侧边的小盖子注水
要注意水量不要超过最高水位线。


还附赠了一套墙面悬挂的配件——免钉胶和螺丝固定两种
如果厨房台面实在没有位置摆放,就可以选择安装在墙面上。

像这样一款高性能 + 易清洁 + 不占地的冰厨宝,这波不冲真的亏到家了!

以前的茶都白喝了!
巴森萃茶机
原价¥399
普象价¥299
很多人对喝茶这件事,大都停留在泡茶阶段。
其实在萃茶技艺突飞猛进,茶也可以像浓缩咖啡一样被萃取出来。
像我喝茶就一直用这台巴森萃茶机,茶水入口清甜,回甘不苦涩。

养生壶“煮出味道”,而这个萃茶机,则是为了让你“随时喝到好味”
它萃好的茶,直接就是茶水分离+保温的状态,少了久泡、久煮的苦涩,也能最大程度保留二泡、三泡的风味,对得起咱们买来的好茶。

它的上层保温最长12小时,下层保温最长6小时,想喝的时候抬手就倒,无论什么时候喝,温度、口感都是最好的。
镀银出水拨杆,质感很好,用久不变色。

它泡茶好喝,是因为它是“有手法”的:
上部316不锈钢茶漏,添加茶叶。

下部分蒸汽喷淋,下蒸上淋,对茶的萃取更透彻,也能更好地释放老白茶、普洱等这类发酵类茶的香气,味道也更有层次。


不加茶漏直接用来煮果茶也能很好的锁住营养。
煮出来的果茶清甜又浓郁。














